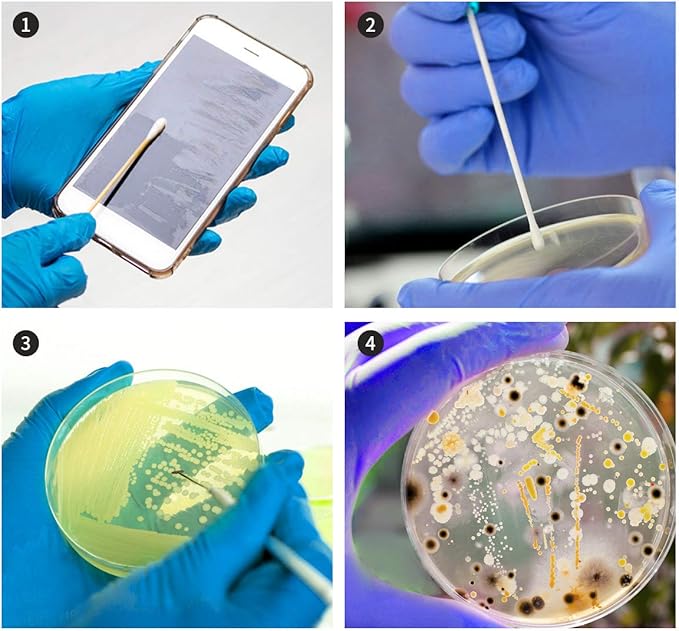
Bacteria Science Kit Petri Dishes with Agar and Swabs | Top Science Fair Project Bacteria Growing Kit | Prepoured LB-Agar Plates and Cotton Swabs | STEM for Kids Aged 6 7 8 9 10 Girls Boys Gifts

1
/
의
6
DALOS+DREAM
Bacteria Science Kit Petri Dishes with Agar and Swabs | Top Science Fair Project Bacteria Growing Kit | Prepoured LB-Agar Plates and Cotton Swabs | STEM for Kids Aged 6 7 8 9 10 Girls Boys Gifts
Bacteria Science Kit Petri Dishes with Agar and Swabs | Top Science Fair Project Bacteria Growing Kit | Prepoured LB-Agar Plates and Cotton Swabs | STEM for Kids Aged 6 7 8 9 10 Girls Boys Gifts
정가
$27.27 USD
정가
할인가
$27.27 USD
수량
픽업 사용 가능 여부를 로드할 수 없습니다.
Share